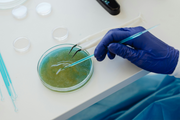

TOP RATED CBD AND HEMP DISTINATION IN FLORIDA


Health Synergy is a long-established and reputable CBD dispensary that offers the public the highest quality organic hemp products available. All of our Hemp is sourced from our farms in Colorado, California and Oregon. Our plants are grown organically; hence, we are the perfect answer to your “best CBD or Hemp near me” query.
Check Out Our Lab Test Certifications
ALL OF OUR PRODUCTS ARE MADE WITH THE HIGHEST QUALITY CERTIFIED CBD, AND ALL NATURAL ORGANIC INGREDIENTS TO ENSURE CONSISTENT HIGH STANDARDS.
Our Products

FULL SPECTRUM & THC FREE PRODUCTS
Health Synergy’s products come in the form of full spectrum and broad spectrum (THC-free) CBD to meet the needs of each customer and patient. Full spectrum hemp products contain CBD as well as other minor cannabinoids, including a small percentage of THC (less than or equal to 0.3%) and terpenes to give customers and patients the most therapeutic effect. Our broad spectrum products are THC-free and they contain other minor cannabinoids and terpenes.



































